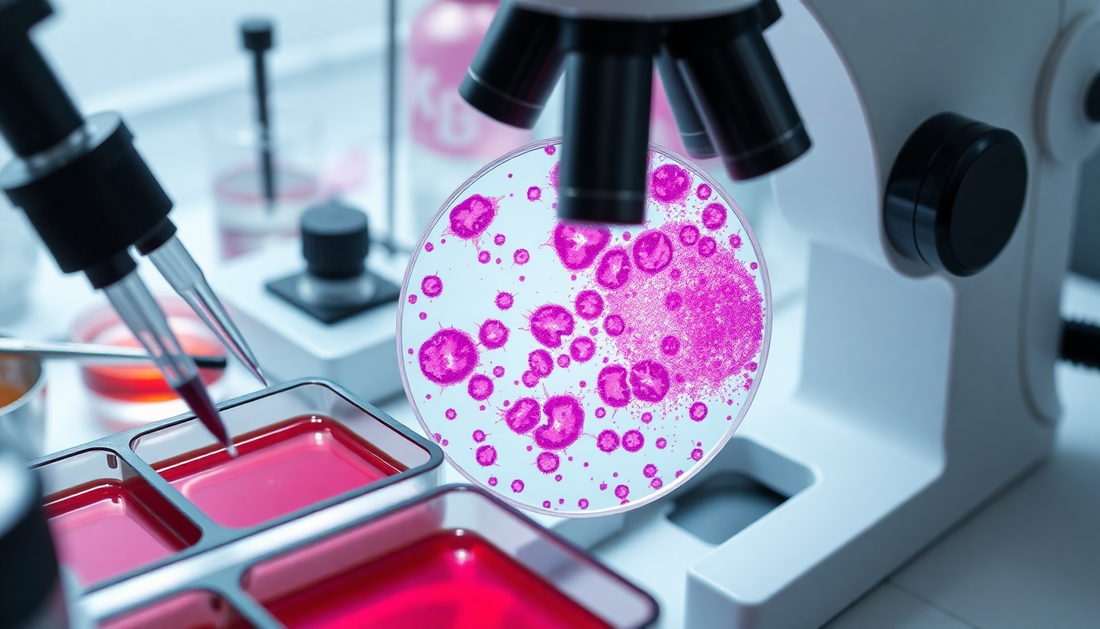
Eosin als Farbstoff – Seine Rolle in Histologie und Labordiagnostik

Eosin als Farbstoff – Seine Rolle in Histologie und Labordiagnostik
Eosin, ein rötlicher Farbstoff, hat sich in der Medizin und Forschung als unverzichtbares Werkzeug etabliert. Dieser Artikel beleuchtet die vielfältigen Anwendungen von Eosin in der Histologie und Labordiagnostik und zeigt, wie dieser Farbstoff unser Verständnis von Zellen und Geweben erweitert.
Die Geschichte von Eosin
Eosin wurde erstmals 1874 von dem deutschen Chemiker Adolf von Baeyer synthetisiert. Der Name "Eosin" leitet sich vom griechischen Wort "eos" für "Morgenröte" ab, da der Farbstoff eine rötlich-pinke Färbung aufweist. Ursprünglich wurde Eosin als Farbstoff in der Textilindustrie verwendet, doch schon bald erkannten Mediziner und Wissenschaftler sein Potenzial für die Mikroskopie und Laboranalysen.
Anwendungen in der Histologie
In der Histologie, der Lehre vom Feinbau der Gewebe, ist Eosin ein unverzichtbarer Farbstoff. Zusammen mit Hämatoxylin, einem blauen Farbstoff, bildet Eosin die Grundlage der sogenannten Hämatoxylin-Eosin-Färbung (HE-Färbung). Diese Methode ermöglicht es, Zellstrukturen und -bestandteile unter dem Mikroskop sichtbar zu machen und zu unterscheiden.
Färbung von Zellstrukturen
Eosin färbt vor allem basophile Strukturen, also solche, die eine hohe Affinität zu Säuren haben. Dazu gehören:
- Zytoplasma: Eosin färbt das Zytoplasma der Zellen rötlich an, wodurch deren Umrisse und Struktur deutlich hervortreten.
- Kollagenfasern: Das Bindegewebe, das Organe und Gewebe zusammenhält, wird durch die Eosin-Färbung rosa bis rot dargestellt.
- Erythrozyten: Die roten Blutkörperchen erscheinen unter dem Mikroskop durch die Eosin-Färbung leuchtend rot.
Diese selektive Färbung ermöglicht es Pathologen und Histologen, Zelltypen und Gewebestrukturen präzise zu identifizieren und zu analysieren.
Kontrastierung mit Hämatoxylin
Während Eosin basophile Strukturen anfärbt, färbt Hämatoxylin vor allem azidophile, also säureliebende Strukturen an. Dazu gehören:
- Zellkerne: Die Zellkerne werden durch Hämatoxylin dunkelblau bis violett gefärbt, was ihre Form und Lage innerhalb der Zelle deutlich macht.
- Nukleinsäuren: Die im Zellkern und Zytoplasma befindlichen Nukleinsäuren (DNA und RNA) werden durch Hämatoxylin angefärbt.
Durch die Kombination von Eosin und Hämatoxylin in der HE-Färbung entsteht ein hoher Kontrast zwischen Zellkernen, Zytoplasma und extrazellulären Strukturen. Dies erleichtert die Untersuchung und Interpretation von Gewebeschnitten erheblich.
Anwendungen in der Labordiagnostik
Neben der Histologie findet Eosin auch in der klinischen Labordiagnostik vielfältige Verwendung. Hier dient der Farbstoff vor allem der Sichtbarmachung und Differenzierung von Blutzellen.
Färbung von Blutausstrichen
In der Hämatologie, der Lehre vom Blut, wird Eosin zur Färbung von Blutausstrichen eingesetzt. Dabei werden dünne Schichten von Blut auf einem Objektträger ausgestrichen und mit Eosin-Lösungen behandelt. Anschließend können die verschiedenen Blutzelltypen unter dem Mikroskop identifiziert und gezählt werden:
- Erythrozyten: Die roten Blutkörperchen erscheinen rot gefärbt.
- Leukozyten: Die weißen Blutkörperchen lassen sich anhand ihrer unterschiedlichen Färbemuster differenzieren, z.B. Lymphozyten, Monozyten, Granulozyten.
- Thrombozyten: Die Blutplättchen sind als kleine, rötlich gefärbte Partikel sichtbar.
Diese Differenzierung ist wichtig für die Diagnose von Bluterkrankungen wie Anämien, Leukämien oder Gerinnungsstörungen.
Färbung von Bakterien und Parasiten
Eosin findet auch Anwendung in der mikrobiologischen Diagnostik. Bakterien und Parasiten können damit angefärbt werden, um sie unter dem Mikroskop besser sichtbar zu machen und zu identifizieren. Beispiele sind:
- Färbung von Malariaerregern in Blutausstrichen
- Anfärbung von Bakterien in Urin- oder Stuhlproben
- Darstellung von Pilzstrukturen in Hautabstrichen
Die Eosin-Färbung ermöglicht es Medizinisch-Technischen Assistenten und Ärzten, Infektionen schnell und zuverlässig zu erkennen und die richtige Behandlung einzuleiten.
Eosin in der Forschung
Neben der klinischen Diagnostik findet Eosin auch in der biomedizinischen Forschung vielfältige Anwendung. Hier dient der Farbstoff vor allem der Visualisierung und Untersuchung von Zellstrukturen und -funktionen.
Fluoreszenzmikroskopie
In der Fluoreszenzmikroskopie wird Eosin als Fluoreszenzfarbstoff eingesetzt. Dabei bindet der Farbstoff an bestimmte Zellbestandteile und leuchtet unter UV-Licht auf. Dies ermöglicht es, zelluläre Strukturen wie Zellkerne, Zytoskelett oder Organellen hochauflösend darzustellen und zu analysieren.
Immunhistochemie
In der Immunhistochemie wird Eosin häufig als Gegenfärbung verwendet. Nachdem spezifische Zielstrukturen wie Proteine oder Enzyme mit Antikörpern markiert wurden, dient Eosin dazu, die Gewebestruktur insgesamt sichtbar zu machen. So lassen sich Rückschlüsse auf die Lokalisation und Verteilung der untersuchten Moleküle ziehen.
Zellkulturanalysen
Auch in der Zellkulturforschung findet Eosin Anwendung. Der Farbstoff kann verwendet werden, um Zellen anzufärben und deren Vitalität, Proliferation oder Morphologie zu untersuchen. So lassen sich beispielsweise Zytotoxizitätstests oder Apoptose-Analysen durchführen.
Fazit
Eosin hat sich als vielseitiger und unverzichtbarer Farbstoff in der Medizin und Forschung etabliert. Von der Histologie über die Labordiagnostik bis hin zur Zellbiologie ermöglicht der rötliche Farbstoff tiefe Einblicke in die Struktur und Funktion von Zellen und Geweben. Dank seiner selektiven Färbeeigenschaften und der Kombination mit anderen Farbstoffen wie Hämatoxylin hat Eosin maßgeblich zum Fortschritt in der Medizin und Biologie beigetragen.